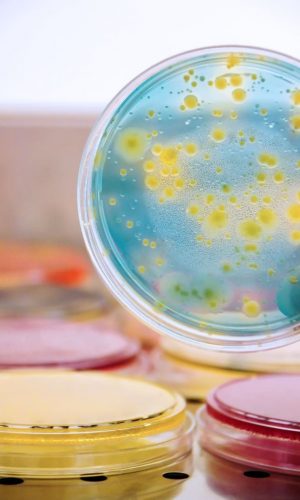

La biotecnología es un campo basado en la biología que aprovecha los procesos celulares y biomoleculares para desarrollar tecnologías y productos innovadores. Utiliza sistemas biológicos y microorganismos vivos para obtener soluciones específicas en sectores como la agricultura, los alimentos, la industria farmacéutica y el medio ambiente.
Desde la mejora de cultivos y la producción de alimentos más seguros, hasta el desarrollo de terapias avanzadas y la protección del medio ambiente, la biotecnología ofrece herramientas poderosas para mejorar nuestras vidas y abordar los desafíos globales de manera sostenible.
En Europa Biotechnology, nos dedicamos al desarrollo tecnológico de microorganismos a través de fermentaciones sólidas y líquidas, con el objetivo de obtener productos de alto valor para diversas industrias.
Trabajamos en los sectores farmacéutico, ambiental, agrícola y alimentario, optimizando microorganismos como hongos, levaduras, algas y bacterias, para ofrecer soluciones eficientes y rentables.
Nuestra misión es seleccionar el microorganismo más adecuado para obtener compuestos biológicos específicos o funciones biológicas particulares. Además, nos especializamos en la formulación económica de medios nutritivos industriales, brindando asesoramiento sobre el mantenimiento de microorganismos y su escalado a nivel industrial mediante fermentaciones sólidas o líquidas.
Entendemos que el inicio en el sector biotecnológico puede ser desafiante para muchas empresas, por lo que también nos dedicamos a conseguir equipos usados de laboratorio e industriales, con el objetivo de ayudar a reducir costos a aquellas empresas que están dando sus primeros pasos en esta industria.
Además, ofrecemos acompañamiento integral a las empresas en proyectos de microbiología industrial, desde las etapas iniciales hasta la producción a escala industrial.

La fermentación sólida es un proceso en el cual los microorganismos crecen en ambientes sólidos. Se basa en una mezcla de agua (50% a 70%) y sustrato de origen vegetal (30% a 50%), como desechos agrícolas. Esta técnica ofrece una ventaja económica significativa en términos de inversión, ya que requiere menos equipos y costos de mantenimiento. Es ampliamente utilizada para la obtención de metabolitos microbianos de interés en diversas industrias, como la alimentaria, agrícola y farmacéutica. La fermentación sólida es especialmente adecuada para el aprovechamiento de residuos orgánicos y la producción de enzimas, biofertilizantes, alimentos fermentados y otros productos de alto valor.

La fermentación líquida es una metodología utilizada en la fabricación de biomoléculas a partir de caldos nutritivos. En este proceso, los microorganismos se cultivan en recipientes con controladores de temperatura, pH y otros parámetros. Aunque la fermentación líquida requiere una inversión mayor en términos de infraestructura y equipos, ofrece una mayor flexibilidad y control sobre las condiciones de cultivo. Es ampliamente empleada en la producción de productos biotecnológicos como proteínas terapéuticas, enzimas industriales, antibióticos, vitaminas y otros compuestos de interés. La fermentación líquida permite una escala de producción más grande y una mayor reproducibilidad, lo que la convierte en una técnica clave en la industria farmacéutica, alimentaria y química.